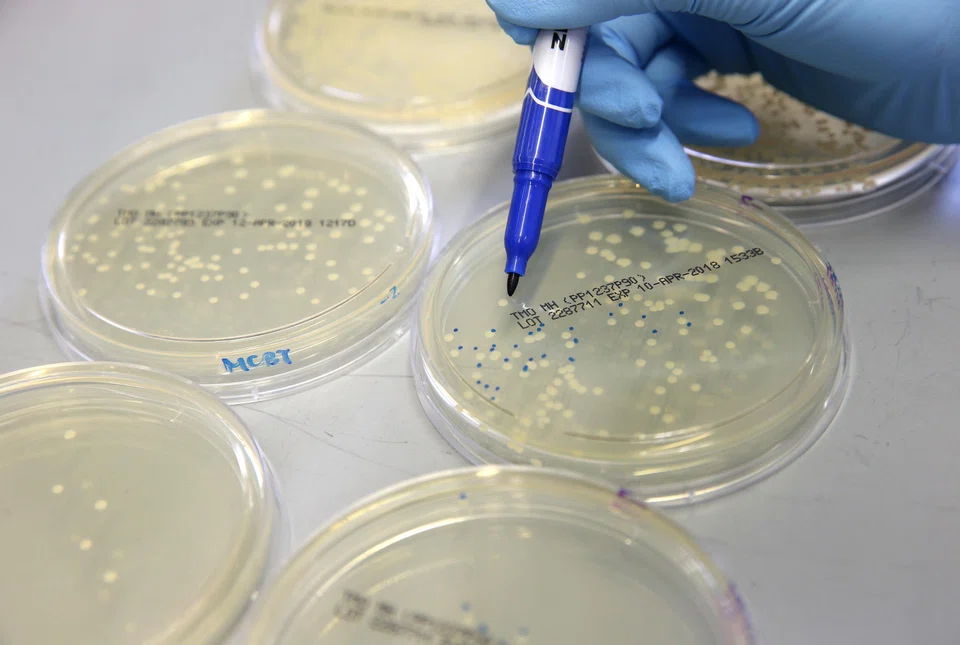
There is urgent need for new approaches to tackle antibiotic resistance and biofilms, particularly as no new classes of antibiotics have been discovered since the 1980s.

How AI is joining the fight against superbugs
Scientists are exploring new strategies to win the war against potent microbes
INVISIBLE to the naked eye, bacteria are constantly evolving in their quest for survival.
Over the years, the misuse and overuse of antibiotics have inadvertently fuelled the rise of antibiotic-resistant bacteria, also known as “superbugs”.
These superbugs are equipped with ingenious defence mechanisms, such as forming castles of slime called biofilms, in which bacterial communities are well-protected against attacks from antibiotics and the immune system.
TRENDING NOW

Malaysian tycoon Vincent Tan’s sell-downs point to pruning rather than an exit plan

Taiwan’s wealthy seeks diversification to Singapore, sparking private banking race: Bloomberg

Serenity Park condo owners lower asking price to S$440 million in second shot at collective sale

SGX to roll out post-trade custody model, changes to bid mechanics in July, cut board lots in October